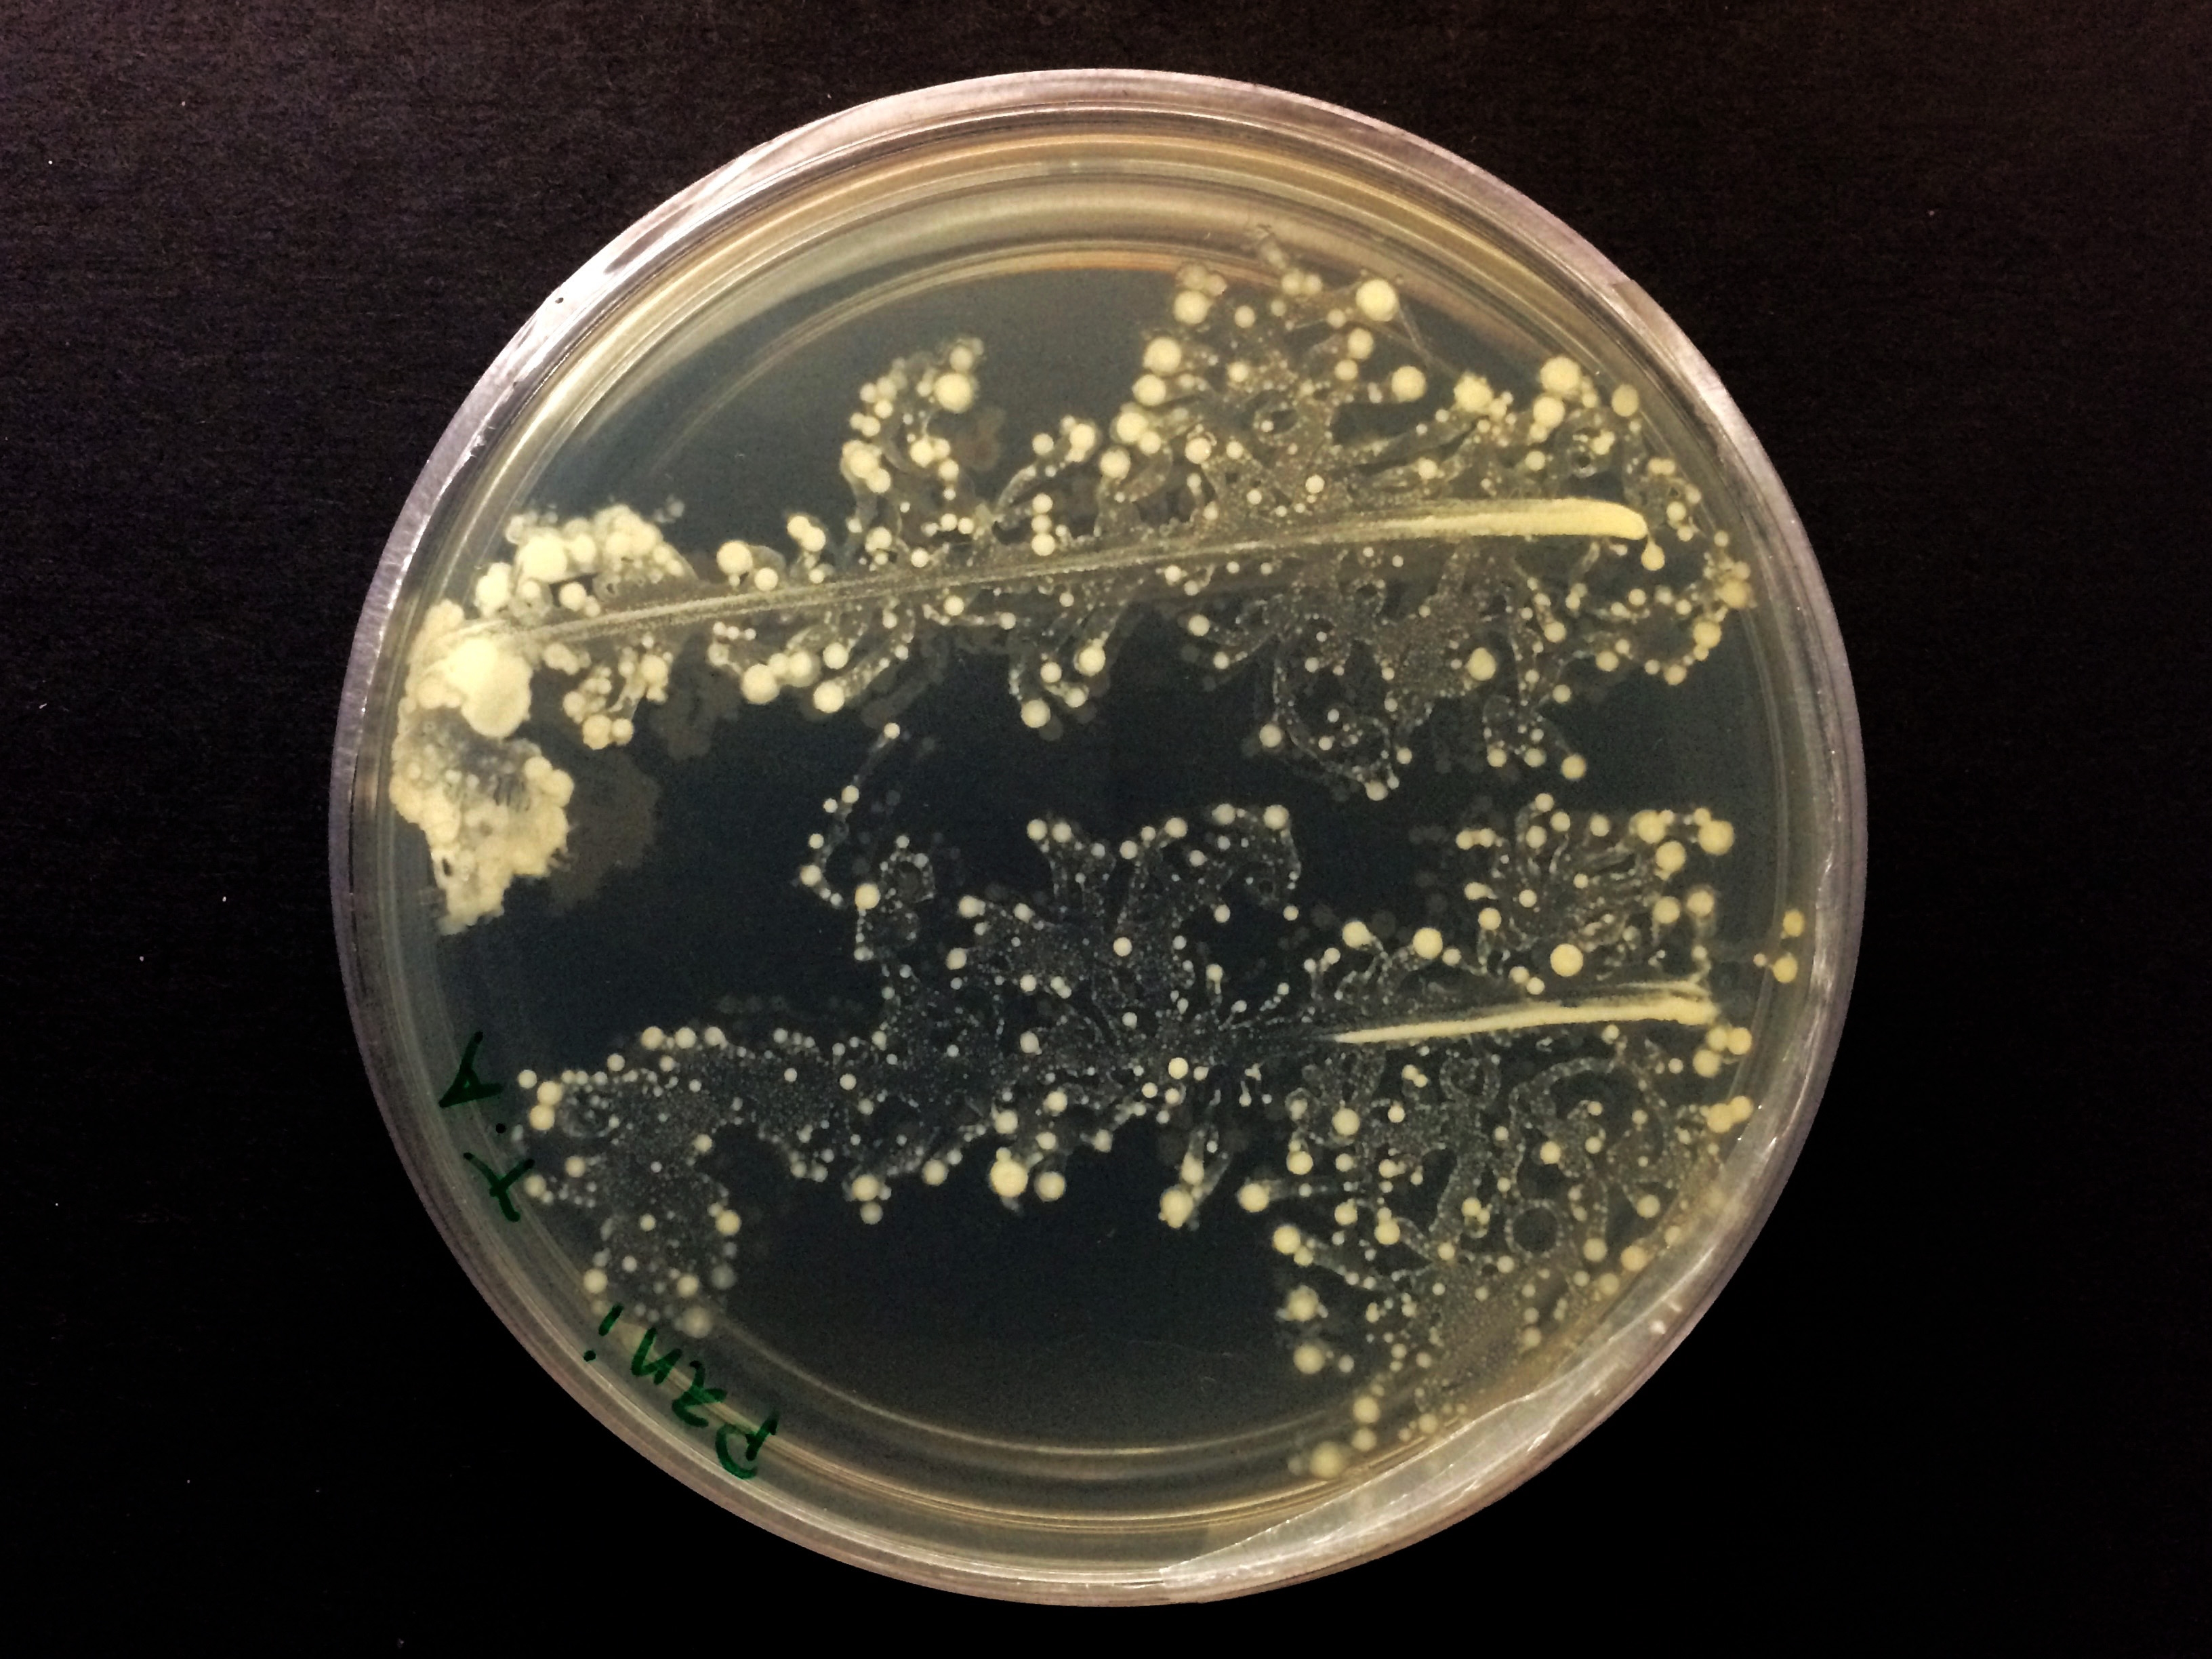

Resultats de la cerca
Es mostren 11 resultats
totipotent
Biologia
Dit del blastòmer que, un cop aïllat, pot desenvolupar un embrió complet.
retrovirus
Biologia
Grup de virus ARN d’infecció lenta que es caracteritzen per transcriure el seu genoma d’ARN a ADN.
La infecció té lloc per l’acció de l’enzim transcriptasa inversa, present en tots els retrovirus, amb el qual es fixen i el seu genoma és introduït en el cellular, on es replica utilitzant el mateix mecanisme cellular o es manté en forma latent durant un temps variable i indefinit El primer virus humà d’aquest grup identificat fou l’HTLV-I Human T-Cell Lymphotropic Virus type I , aïllat el 1978, i el més conegut és el virus de la immunodeficiència humana VIH, causant de la sida Les infeccions per retrovirus poden ésser asimptomàtiques o bé causar diverses afeccions com ara…
terapèutica gènica
Biologia
Medicina
Terapèutica per a malalties genètiques que es basa en la transferència de còpies normals dels gens defectuosos als individus afectats perquè produeixin quantitats suficients del producte gènic normal.
Per a poder realitzar terapèutica gènica cal tenir aïllat el gen normal, disposar de cèllules de l’individu afectat on es pugui inserir, com per exemple cèllules del moll de l’os, disposar d’un mètode d’introducció del gen i que les cèllules, un cop reintroduïdes en el pacient, produeixin la proteïna normal en quantitat suficient i al lloc correcte En un procés de terapèutica gènica primer s’obtenen cèllules del pacient, a continuació s’hi introdueix el gen fent servir, generalment, vectors vírics, se seleccionen les cèllules que han incorporat el gen i produeixen nivells normals…
colistina
Biologia
Farmàcia
Antibiòtic natural de la família de les polimixines, produït pel Bacillus colistinus
, aïllat originalment del sòl, al Japó.
De natura polipeptídica i d’estructura parcialment cíclica, és emprat com a antibacterià intestinal
Titanospirillum velox
Biologia
Bacteri espiril aïllat als tapissos microbians del delta de l’Ebre, molt més gran que qualsevol altre del seu grup.
Aquest espiril, el nom del qual significa ‘espiril gegant i veloç’, fou descobert a la península dels Alfacs per investigadors de la Universitat de Barcelona i de la Universitat de Massachusetts Presenta dos plomalls de flagells, un a cada extrem, amb més de 60 flagels cadascun que permeten que es desplaci a gran velocitat
antibiòtic

Esquema d’una instal·lació per a la producció de penicil·lina
© fototeca.cat
Biologia
Farmàcia
Substància química produïda per microorganismes com a resultant d’una biosíntesi específica, capaç, a baixes concentracions, d’inhibir el creixement d’altres microorganismes o d’eliminar-los.
En un sentit més ampli, hom considera que també ho són les substàncies químiques obtingudes sintèticament en modificar l’estructura d’un antibiòtic, i que posseeixen igualment efectes antimicrobians Els antibiòtics solen ésser sintetitzats, i alliberats al medi com a forma d'antibiosi, per fongs floridures i per diversos organismes més o menys adaptats també a viure al sòl actinomicets i bacils esporuladors, bé que molts altres organismes també en produeixen La seva estructura química, molt sovint cíclica, és en cada cas diferent i específica, i molt sovint té caràcter glucídic o proteic…
colònia
Colònia formada a partir del cultiu de Paenibacillus
Biofablab PUC
Biologia
Massa de cèl·lules bacterianes originades per la reproducció d’un bacteri aïllat en un medi de conreu sòlid o fins i tot líquid, com en el cas dels actinomicets.
electromiografia
Biologia
Mètode utilitzat per a enregistrar els canvis de potencial elèctric que es produeixen en un múscul aïllat o en un grup muscular quan es contreu espontàniament o per inducció amb estímuls generalment elèctrics.
microbiologia
Biologia
Part de la biologia que estudia els microorganismes.
Aquesta disciplina s’ocupa de la descripció dels nombrosos tipus de microorganismes protozous, algues, fongs, bacteris, rickèttsies, virus, etc, de l’estudi de llurs condicions i medis de vida, de llurs relacions amb la natura, de tots aquells casos en què els microorganismes actuen com a patògens en l’home, els animals i les plantes, dels processos industrials que mitjançant microorganismes produeixen aliments llevats de panificació, formatges, begudes alcohòliques, maduració d’embotits, etc i de la producció industrial d’antibiòtics, aminoàcids i dissolvents orgànics També és una ciència…